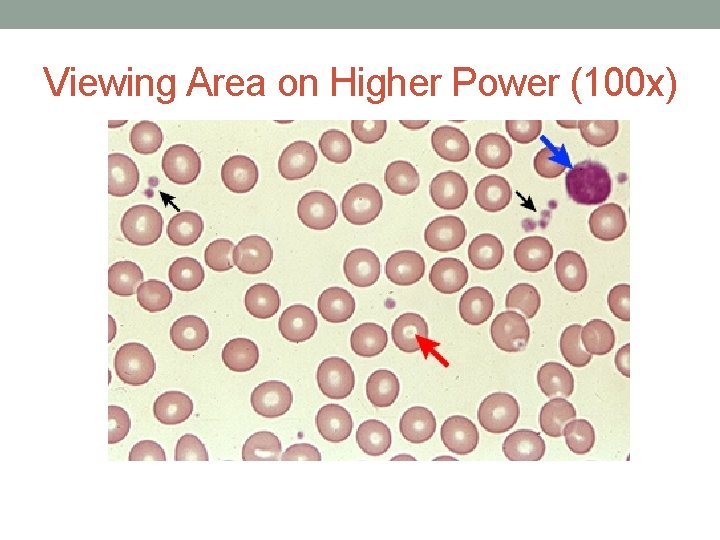
Viewing Area on Higher Power (100 x)  Viewing Area on Higher Power (100 x)
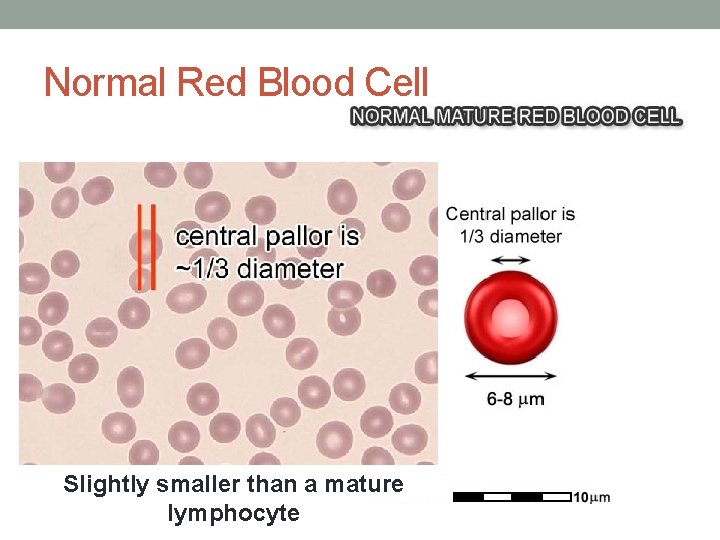
Normal Red Blood Cell Slightly smaller than a mature lymphocyte  Normal Red Blood Cell Slightly smaller than a mature lymphocyte
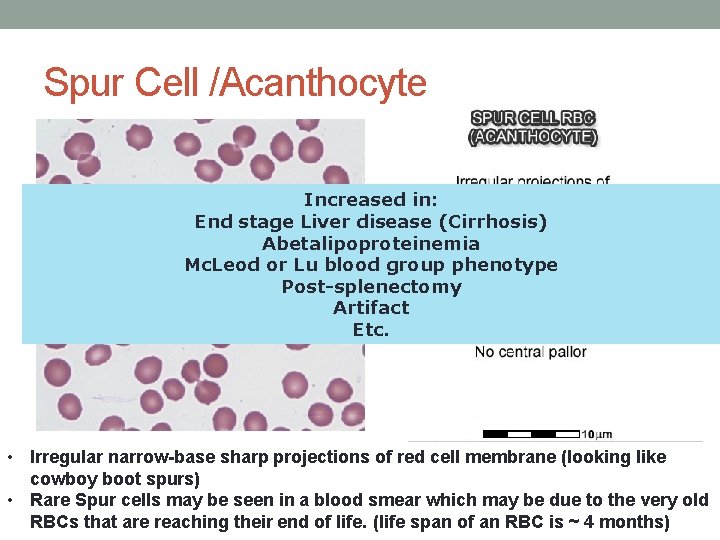
Spur Cell /Acanthocyte Increased in: End stage Liver disease (Cirrhosis) Abetalipoproteinemia Mc. Leod or Spur Cell /Acanthocyte Increased in: End stage Liver disease (Cirrhosis) Abetalipoproteinemia Mc. Leod or
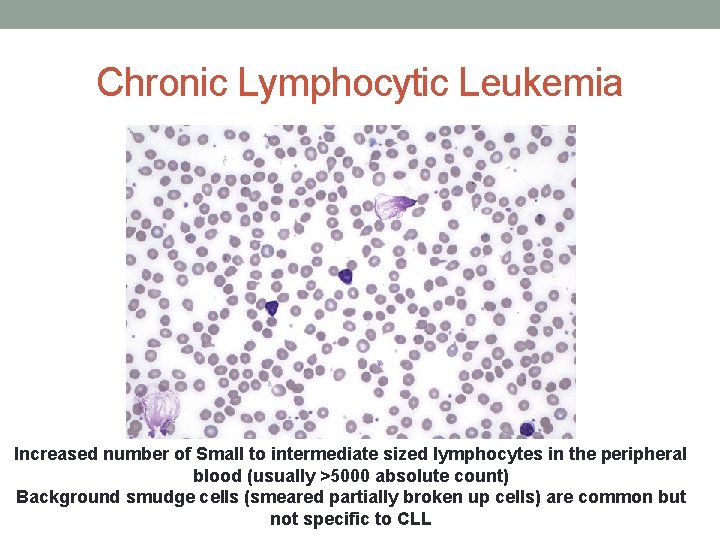
Chronic Lymphocytic Leukemia Increased number of Small to intermediate sized lymphocytes in the peripheral Chronic Lymphocytic Leukemia Increased number of Small to intermediate sized lymphocytes in the peripheral
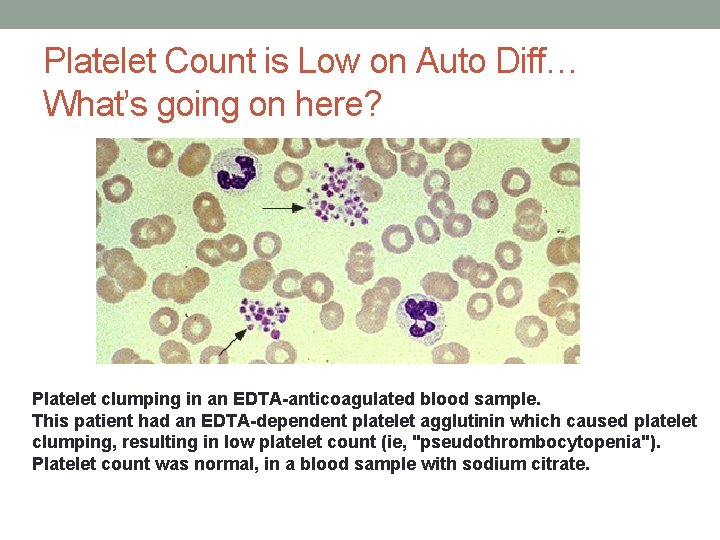
Platelet Count is Low on Auto Diff… What’s going on here? Platelet clumping in Platelet Count is Low on Auto Diff… What’s going on here? Platelet clumping in
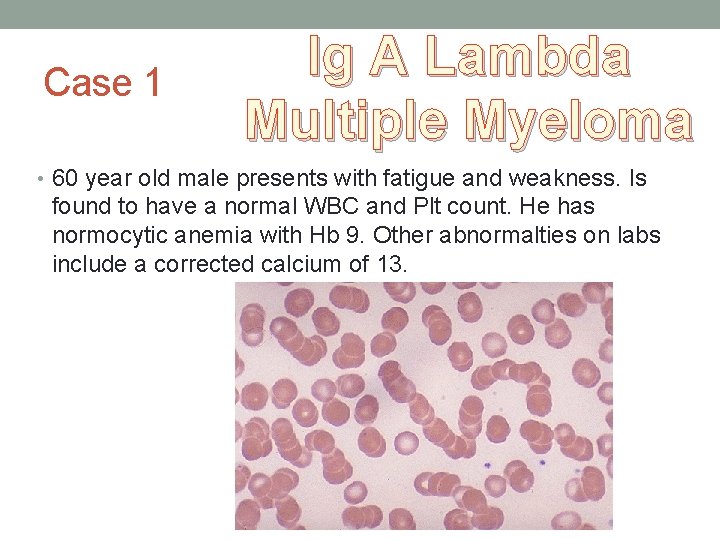
Case 1 Ig A Lambda Multiple Myeloma • 60 year old male presents with Case 1 Ig A Lambda Multiple Myeloma • 60 year old male presents with
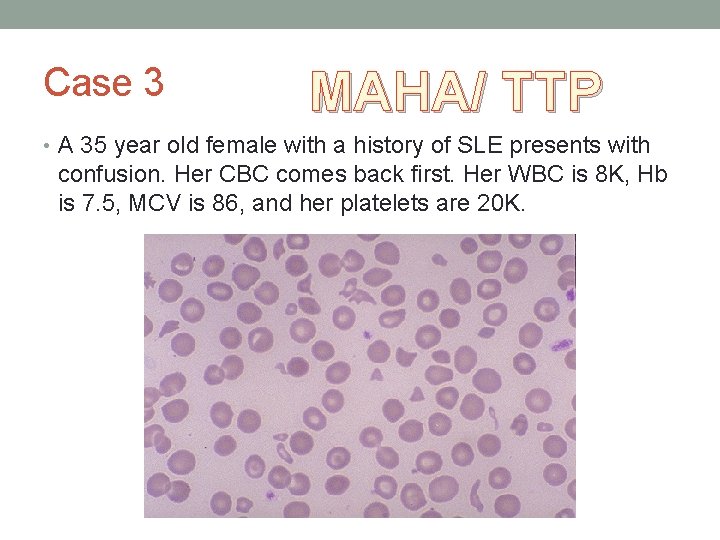
Case 3 MAHA/ TTP • A 35 year old female with a history of Case 3 MAHA/ TTP • A 35 year old female with a history of
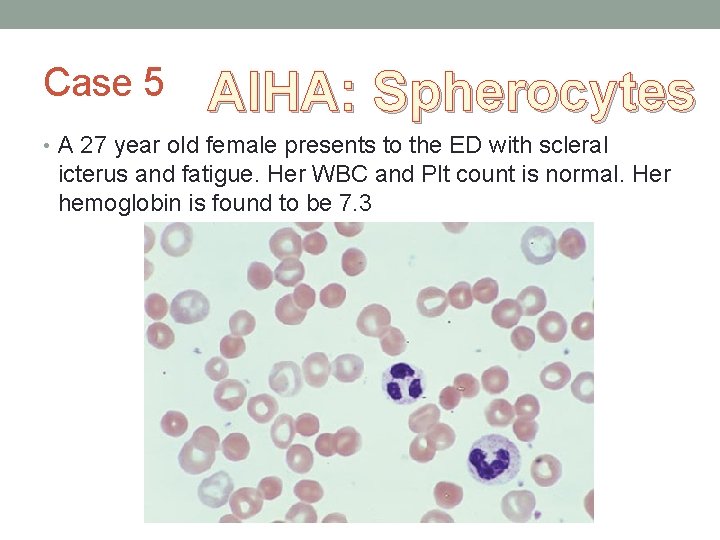
Case 5 AIHA: Spherocytes • A 27 year old female presents to the ED Case 5 AIHA: Spherocytes • A 27 year old female presents to the ED
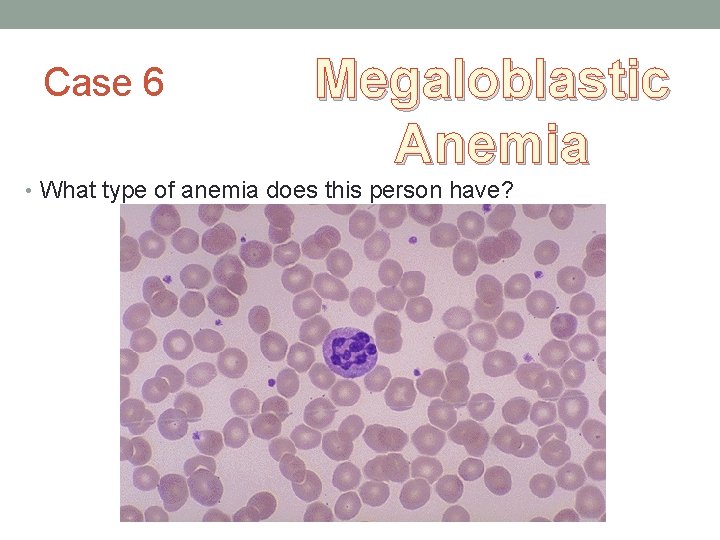
Case 6 Megaloblastic Anemia • What type of anemia does this person have?  Case 6 Megaloblastic Anemia • What type of anemia does this person have?
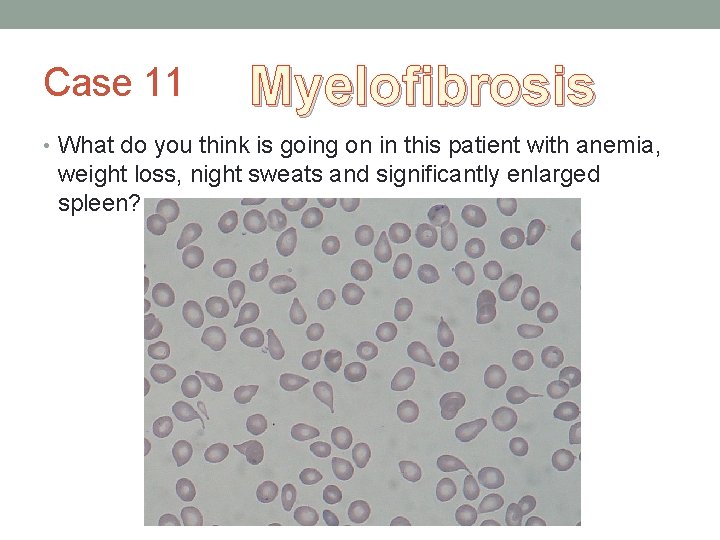
Case 11 Myelofibrosis • What do you think is going on in this patient Case 11 Myelofibrosis • What do you think is going on in this patient

INTRODUCTION TO THE PERIPHERAL BLOOD SMEAR Rafi Ahmed

INTRODUCTION TO THE PERIPHERAL BLOOD SMEAR Rafi Ahmed Hematology Oncology 6 -12 -14

To smear or not to smear? • Powerful diagnostic tool • A window into the functional status of the bone marrow • A noninvasive view into the factory of all blood elements. • Most important when assessing cytopenias • Anemia • Leukopenia • Thrombocytopenia • Not required in all situations • (i. e slam dunk situations iron deficiency with low MCV) • Extremely helpful in evaluating: • Hemolytic anemia – Review of red cell morphology may identify the cause of erythrocyte destruction • Thrombocytopenia – Distinguishing between increased platelet consumption and reduced platelet production can often be made through review of platelet size • White cell disorders – presence of blasts, auer rods etc.


How a PBS is made • A drop of blood is placed on one end of a slide • A spreader slide is used to disperse the blood over the slide's length. • Ideally would want a monolayer, where the cells are spaced far enough apart to be counted and differentiated.

Peripheral Blood Smear • The slide is left to air dry • Then fixed by immersing it briefly in methanol. The fixative is essential for good staining and presentation of cellular detail. • After fixation, the slide is stained: Wright-Giemsa

Finding an Optimal Viewing Area • Scan entire slide under lower power (10 x-40 x) • Enables selection of an optimal area • Look for an area where the red blood cells are just touching and demonstrate central pallor • Then move to higher power (100 x with oil)

What is consider and ideal viewing area? Blood cells are clumped or unevenly dispersed. Individually separated from one another and fairly uniformly dispersed Jumbled together and touching one another.
Viewing Area on Higher Power (100 x)

Times when viewing area is abnormal Rouleaux formation due to elevated levels of plasma proteins Peripheral blood smear from a patient with multiple myeloma shows red blood cell rouleaux giving the appearance of stacked coins. Cold agglutinin hemolytic anemia shows marked red blood cell agglutination into irregular clumps Or Sometimes you just have a bad smear….

Overview of hematopoeisis

RBC Maturation

Red Blood Cells • Look at typical cell size • Microcytosis • Small RBC with MCV <80 f. L • Macrocytosis • Abnormally large RBC with MCV >100 f. L. • Anisocytosis: Is there variation in cell size? • Are all cells nearly the same? • Are many cells bigger, or smaller, than the typical cell? Are there cells in both bigger and smaller categories? • Poikilocytosis: Is there variation in cell shape? • Do many cells appear in any shape that is dramatically different from round, such as pointy? • Is there variation in cell texture/color. • Do all cells stain similarly pink, or do some contain basophilic patches or granules? • Hypochromia • Enlarged area of pallor due to cell’s decreased hemoglobin content • Polychromasia • Bluish/purple hue in young RBCs due to residual RNA

Abnormalities in RBC Shape

Abnormalities in RBC Shape
Normal Red Blood Cell Slightly smaller than a mature lymphocyte

Microcytosis "Puny" for Pyridoxine deficiency "T" for Thalassemia "I" for Iron deficiency anemia "C" for Chronic disease anemia (sometimes): AKA Anemia of Chronic Disease "S" for Sideroblastic anemia (e. g. Lead poisoning): sometimes • Slightly smaller than a normal mature RBC which correlates to the MCV of <80 f. L • Pallor is usually present • Can be hypochromic (central pallor greater than 1/3 of cell diameter)

Macrocytosis Vitamin B 12 or folate deficiency Chemotherapy (e. g. Methotrexate) Liver disease Thyroid disease MDS • Slightly larger than a normal mature RBC which correlates to the MCV of >100 f. L • Round to oval in shape
Spur Cell /Acanthocyte Increased in: End stage Liver disease (Cirrhosis) Abetalipoproteinemia Mc. Leod or Lu blood group phenotype Post-splenectomy Artifact Etc. • Irregular narrow-base sharp projections of red cell membrane (looking like cowboy boot spurs) • Rare Spur cells may be seen in a blood smear which may be due to the very old RBCs that are reaching their end of life. (life span of an RBC is ~ 4 months)

Burr Cell / Echinocyte Increased in: Artifact (e. g. older blood specimen) Uremia (e. g. chronic renal disease) Liver disease Hyperlipidemia Etc. • Regular broader-base short blunt projections of red cell membrane • Most often they are due to an artifact of smear preparation. Also one must inquire about the age of the blood sample.

Schistocytes Increased in: Microangiopathic Hemolytic Anemia (e. g. as seen in DIC, TTP, or HUS) Severe burns Mechanical valve-induced Uremia Malignant hypertension • Different RBC fragment variants (helmet cell, irregular fragments, etc. ) • Usually associated with an intravascular hemolytic process (as opposed to spherocytes which are usually associated with an extravascular hemolytic process)

Bite Cell Increased in: G 6 PD deficiency Unstable hemoglobin disorders Oxidative drug-effect Usually slightly smaller than a normal RBC The RBC has a "bitten" appearance (like a bitten apple)

Elliptocyte / Ovalocyte Increased in: Severe iron deficiency anemia Hereditary elliptocytosis Same size or slightly larger than a normal RBC Usually longer and narrower than normal RBC Usually has a central pallor

Spherocyte Increased in: Hereditary spherocytosis Autoimmune hemolytic anemia Very Round No central pallor

Target Cell Increased in: Thalassemia Hemoglobinopathies (C, SC, or E disease) Post-splenectomy Liver disease Artifact of slow drying of blood smear Bull's eye appearance (resembles the Target sign) Increased surface membrane to volume ratio gives rise to a central darker hemoglobinized region within the area of central pallor

Sickle Cell Banana-shaped RBC with two pointed ends An underlying mutation in the hemoglobin Beta chain (The hydrophilic residue Glutamate is replaced with the hydrophobic residue Valine) which leads to aggregation of the hemoglobin molecules which ultimately twists the RBC into a sickled shape

Tear Drop • Increased number of tear drop RBCs is a clue to a possible underlying marrow process Increased in: Myelofibrosis Bone marrow infiltration by hematologic or nonhematologic malignancy Artifact of slide preparation (in which all the tails usually point in the same direction) Increased number of tear drop RBCs is a clue to a possible underlying marrow process

Red Cell Agglutination Paroxysmal cold hemoglobinuria Cold agglutinins Elevated serum Ig. M M-spike as in Waldenstom 's macroglobulinemia Plasma cell neoplasm associated with monoclonal Ig. M A cluster of overlapping RBCs (Non-linear overlapping RBCs) Must be evaluated in the appropriate section of the peripheral blood smear (where RBCs are usually not touching each other). Mostly due to reduced zeta potential (Note: the zeta potential between RBCs keeps them apart. Positively charged molecules such as immunoglobulins, that reduces this zeta potential will facilitate RBCs to aggregate or stack on top of each other).

Roleaux Plasma cell Neoplasms (e. g. plasma cell myeloma) Chronic liver disease with hypergammaglobulinemia Chronic infections Chronic inflammation Evaluating the wrong area of a slide (e. g. thick area of a blood smear with pseudo-rouleaux) Mostly due to reduced zeta potential (Note: the zeta potential between RBCs keeps them apart. Positively charged molecules such as immunoglobulins, that reduces this zeta potential will facilitate RBCs to aggregate or stack on top of each other).

RBC Maturation

Polychromasia Increased in: In response to some anemias (e. g. hemolytic anemia or blood loss) Reactive Erythroid hyperplasia Post erythropoeitin therapy Polycythemia Vera Slightly larger than normal mature RBCs Cytoplasm is greyish-blue in color

Red Blood Cell Inclusions • Not all of them!

Howell Jolly Asplenism Smooth round dark blue-purple cytoplasmic inclusion May be centrally located or sometimes in the periphery Composed of fragments of DNA

Basophillic Stippling Lead poisoning Thalassemia Sickle cell anemia MDS Very small (dot-like) Blue or blue-gray granules distributed throughout the cytoplasm of RBCs Composed of ribosomes


Segmented Neutrophil Increased in: Infections (especially bacterial infections) Myeloproliferative disorders (e. g. CML and CNL) Leukemoid reaction Drug-induced 2 -3 x larger than a mature RBC Nucleus is mature and divided into 3 to 5 lobes connected by thin chromatin filaments

Band Neutrophil Increased in: Infections (especially bacterial infections) Myeloproliferative disorders (e. g. CML) Leukemoid reaction Drug-induced 2 -3 x larger than a mature RBC Kidney bean-shaped Nucleus with nucleus indentation (more than 1/2 the diameter indented) and mature chromatin (clumped)

Toxic Granulation Usually associated with: Infection Inflammatory conditions Darker (red/purple) granules are easily noted (similar to the primary granules noted in promyelocytes)

Hypersegmented Neutrophil Usually associated with: Vitamin B 12 deficiency Folate deficiency Nucleus is mature and has >5 lobes connected by thin chromatin filaments

Myeloblast If in blood or increased numbers in bone marrow: Acute myeloid leukemia (AML) Myelodysplastic Syndromes (e. g. RAEB-I or II) Myeloproliferative Neoplasms (e. g. CML with increased blasts) Leukemoid reactions Post GCSF therapy High nuclear to cytoplasmic ratio Round Nucleus with immature chromatin (not clumped) Prominent nucleoli Cytoplasm is scant, gray to pale blue and lacks granules

How can you tell its acute leuk if you see a blast? Hiatus Leukemicus: jump in cell development from an early stage to a late stage with nothing in between Leukemoid Reaction: Full spectrum of granulocytes noted

Normal Lymphocyte Slightly (1. 5 x) larger than a mature RBC

Reactive Lymphocyte Increased numbers in blood may be associated with: Epstein-Barr virus infection (Infectious mononucleosis) CMV infection Other viral Infections Drug reaction Chronic inflammatory disorders (e. g. systemic lupus erythematosis, rheumatoid arthritis) 2 -4 x larger than a mature RBC Increased amount of light blue cytoplasm Cytoplasm is usually indented by surrounding RBCs

Large Granular Lymphocyte If increased in blood or bone marrow: Infection Neoplastic (LGL leukemia) 2 -4 x larger than a mature RBC Cytoplasm is abundant, light blue Pink/red granules in the cytoplasm (hence the term "granular")
Chronic Lymphocytic Leukemia Increased number of Small to intermediate sized lymphocytes in the peripheral blood (usually >5000 absolute count) Background smudge cells (smeared partially broken up cells) are common but not specific to CLL

Acute Lymphoblastic Leukemia 3 -4 x larger than a mature RBC High nuclear to cytoplasmic ratio Cytoplasm is scant, light blue and lacks granules


Monocyte 3 -4 x larger than a mature RBC Kidney shaped Indented Nucleus with mature chromatin (clumped) Cytoplasm is abundant, gray to pale blue and with rare to no granules vacuoles are commonly noted in cytoplasm

Eosinophil Increased in: Allergy-related (e. g. Asthma) Drug reactions Invasive parasitic infections Myeloproliferative neoplasms Hodgkin's and non-Hodgkin's lymphomas Autoimmune disorders (some) 2 -3 x larger than a mature RBC Nucleus is mature and usually with 2 lobes connected by thin chromatin filament More cytoplasm with only secondary granules Secondary (specific) granules are Eosinophilic (Red-Orange)

Basophil 2 -3 x larger than a mature RBC More cytoplasm with only secondary granules Secondary (specific) granules are Basophilic (Blue-Violet) The granules obscure the underlying nucleus Increased in CML

Platelets Increased in Iron deficiency Anemia Splenectomy Acute or chronic inflammation Myeloproliferative Neoplasm (e. g. Essential Thrombocythemia, etc. ) Drug reaction
Platelet Count is Low on Auto Diff… What’s going on here? Platelet clumping in an EDTA-anticoagulated blood sample. This patient had an EDTA-dependent platelet agglutinin which caused platelet clumping, resulting in low platelet count (ie, "pseudothrombocytopenia"). Platelet count was normal, in a blood sample with sodium citrate.
Case 1 Ig A Lambda Multiple Myeloma • 60 year old male presents with fatigue and weakness. Is found to have a normal WBC and Plt count. He has normocytic anemia with Hb 9. Other abnormalties on labs include a corrected calcium of 13.

Case 2 Macrocytosis: B 12 deficiency • 74 year old male comes to your office after seeing another doctor. He states that he was told he was anemic and needed a medication to fix his anemia. While waiting for his CBC to come back, you look at his smear.
Case 3 MAHA/ TTP • A 35 year old female with a history of SLE presents with confusion. Her CBC comes back first. Her WBC is 8 K, Hb is 7. 5, MCV is 86, and her platelets are 20 K.
Case 5 AIHA: Spherocytes • A 27 year old female presents to the ED with scleral icterus and fatigue. Her WBC and Plt count is normal. Her hemoglobin is found to be 7. 3
Case 6 Megaloblastic Anemia • What type of anemia does this person have?

Case 7 Acute Leukemia • 18 year old male presents with gingival bleeding. Found to have a WBC count of 2, Hb of 7, Plts of 10 K.

SS with Asplenia Encapsulated What infections is this person at increased risk for? Organisms Case 8 •

Case 9 AML-M 3 (APML) • 55 year old male presents with significant fatigue, nose bleeding and easy bruising. His CBC shows: WBC of 0. 5 k, Hb 7, Plt 15 k. Found to have an INR of 3

Case 10 CLL • 34 year old asymptomatic male was told to follow up because his recent labs showed he had a high white count. He’s found to have a WBC of 45 k. What’s going on?
Case 11 Myelofibrosis • What do you think is going on in this patient with anemia, weight loss, night sweats and significantly enlarged spleen?

Case 12 CML: BCR/ABL • 30 year old female presents with elevated WBC of 50 K. What simple blood test would confirm the diagnosis?

Case 13 Cold Agglutin HA • 45 year old with history of follicular lymphoma presents with fatigue. Found to have a hemoglobin of 5. 7. What’s going on?

So next time you order a peripheral blood smear…. . Smear

Lets make sure you look at it. Peripheral Blood Smear
- Slides: 65